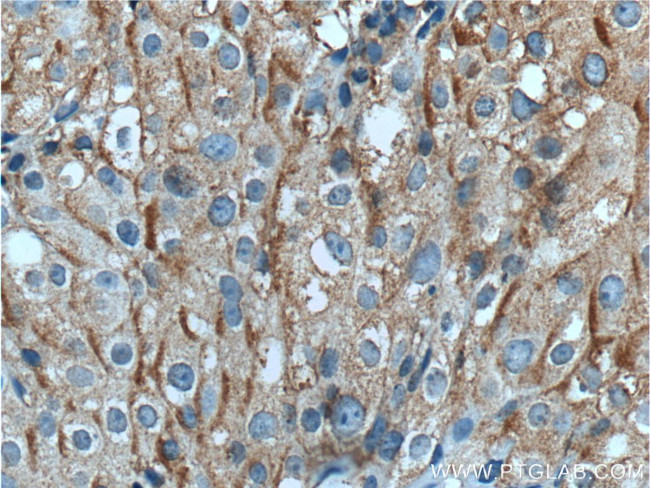
TUSC5 Antibody in Immunohistochemistry (Paraffin) (IHC (P))

Search
Proteintech
TUSC5 Polyclonal Antibody
{{$productOrderCtrl.translations['antibody.pdp.commerceCard.promotion.promotions']}}
{{$productOrderCtrl.translations['antibody.pdp.commerceCard.promotion.viewpromo']}}
{{$productOrderCtrl.translations['antibody.pdp.commerceCard.promotion.promocode']}}: {{promo.promoCode}} {{promo.promoTitle}} {{promo.promoDescription}}. {{$productOrderCtrl.translations['antibody.pdp.commerceCard.promotion.learnmore']}}
产品信息
21556-1-AP
种属反应
宿主/亚型
分类
类型
抗原
偶联物
形式
浓度
规格
纯化类型
保存液
内含物
保存条件
运输条件
产品详细信息
Immunogen sequence: MAHPVQSEF PSAQESGSAA SLDLPEMEIL LTKAENKDDK TLNLSKTLSG PLDLEQNGQG LPFKAISEGH LEAPLPRSPS RASSRRASSI ATTSYAQDQE APRDYLILAV VACFCPV (1-116 aa encoded by BC142615)
靶标信息
TUSC5 (tumor suppressor candidate 5), also known as protein located at seventeen-p-thirteen point three 1, LOST1 or IFITMD3 (interferon-induced transmembrane domain-containing protein D3), is a 177 amino acid multi-pass membrane protein that belongs to the CD225 family. Thought to play a role in fat metabolism, TUSC5 is highly expressed in mammary gland, heart, smooth muscle, skeletal muscle and stomach, with lower levels found in lung and brain.
仅用于科研。不用于诊断过程。未经明确授权不得转售。
篇参考文献 (0)
生物信息学
蛋白别名: brain endothelial cell derived gene-1; Dispanin subfamily B member 1; DSPB1; interferon induced transmembrane protein domain containing 3; Interferon-induced transmembrane domain-containing protein D3; located at seventeen p thirteen point three 1; Protein located at seventeen-p-thirteen point three 1; Trafficking regulator of GLUT4 1; Tumor suppressor candidate 5
基因别名: BEC-1; DSPB1; IFITMD3; LOST1; TRARG1; TUSC5
UniProt ID: (Human) Q8IXB3
Entrez Gene ID: (Human) 286753